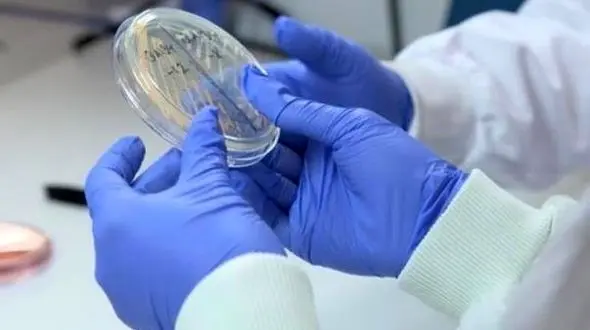
کشتن میکروب ها در 5 دقیقه با این دستکش جدید

انگلیس
1141نتیجه جستجو :
-
سرنوشت محمدبن سلمان هنوز مبهم است
رکنا: با وجود فرمان های حکومتی جدید در ریاض و خبر گفتگوی تلفنی نخست وزیر انگلیس با محمدبن سلمان، همچنان تردیدها در باره وضعیت سلامتی ولیعهد عربستان رفع نشده است.
-
تماس تلفنی ترزا می و محمد بن سلمان درباره ایران
رکنا: سخنگوی دفتر نخستوزیری انگلیس اعلام کرد روز گذشته ولیعهد سعودی و ترزا می به طور تلفنی درباره مسائل مختلف از جمله ایران گفتگو کردند.
-
کشتن میکروب ها در 5 دقیقه با این دستکش جدید
رکنا: محققان دستکش میکروب کش برای کارهای بیمارستانی ساختند.
-
انعطاف پذیرترین هتل دنیا در کدام کشور است؟+تصاویر
رکنا: عجیب ترین و منعطف ترین هتل دنیا در انگلیس واقع شده که توریست ها جذب معماری عجیب آن می شوند.
-
هکر انگلیسی با همکاری یک نوجوان آبادانی حساب ایرانی ها را خالی کرد +عکس
حوادث رکنا: نوجوان آبادانی با دوستی اینترنتی جوان تبعه انگلیس دست به خالی کردن حساب می کردند.
-
عجیبترین مسابقه/ فستیوالی خطرناک که همگان را به خود جذب میکند + فیلم
رکنا: هرساله مسابقه هیجان انگیز و خطرناکی به نام «دنبال کردن پنیر» در یکی از شهرهای انگلیس برگزار میشود.
-
این گاوها لاکچری زندگی می کنند / ماساژور و تشک های آبی برای زندگی رویایی گاوها + عکس
رکنا: مشاهداتی که یک خبرنگار از زندگی شاهانه گاوهای ملکه انگلیس در کاخ ویندسور داشته همه را متحیر کرده است.
-
طرح لباس عروس خانواده سلطنتی انگلیس دزدی از آب در آمد! +عکس
رکنا:طراح مشهور نیوزلندی ادعا کرد که طرح لباس عروس خانواده سلطنتی انگلیس از یکی از طرح های لباس کلکسیون او کپی شده است.
-
قُل دوم «ملکه انگلیس» پیدا شد +تصاویر
رکنا: در طول هفته گذشته تصاویر زیادی از مراسم ازدواج پرنس هری و مگان مارکل در شبکههای اجتماعی منتشر شد. در پی انتشار این تصاویر حاشیههای زیادی در چهارگوشه دنیا دیده و شنیده میشد.
-
در سفر به این کشور صبحانه انگلیسی بخورید
رکنا: صبحانه در کشور انگلیس اهمیت دارد و هتل ها معمولا وعده غذایی کاملی برای توریست ها تدارک می بینند.
-
شباهت جالب و زیاد ملکه انگلیس با رئیس جمهور لبنان+عکس
رکنا: شباهت زیاد ملکه انگلیس با رئیس جمهور لبنان به تازگی خبرساز شده است.
-
چرا ملکه انگلیس لباس های رنگ جیغ می پوشد؟
رکنا: لباس هایی که ملکه انگلیس از جوانی تا دوران پیری به تن کرده است رنگ های شاد یا همان رنگ های جیغ است.الیزابت دوم به خاطر جلوه بیشتر و خودنمایی از این رنگ ها استفاده می کند.
رک پلاس
- علیرضا جی جی : نمی دونم چرا گوگوش و ابی و داریوش گوش می دهید / اینا مغز و شست و شو می دن / عمرا نمیذارن بچم گوش بده
- نگاهی به گیمپلی بازی بتمن لگو + فیلم
- دانلود ریمیکس باشکوه شادمهر و محسن یگانه/ نگو نمیدونی دلم پر از یه نفرین سینه سوز
- با این ویتامین به جنگ سرطان بروید!
- پرستو همسر مهدی طارمی کیست؟ / مادر مهدی این عروس خوزستانی و اجازه نداد پسرش با سحر قریشی ازدواج کند + عکس
- فیلم/ الیکا ناصری : هیچ فامیلی ندارم / در کم جمعیت ترین خانواده جهان به دنیا آمدم / مجری هنگ کرد
- فیلم بررسی عملکرد پراگماتا روی RTX 5060
- تماس مارادونا با سامان احتشامی خواننده و آهنگساز ایرانی / توی جام جهانی احتشامی همه فکر می کردند من مارادونام صف واستادن امضا بگیرن
- دانلود آهنگ باشکوه محسن یگانه / آهنگ عاشقانه ولی بازم دوست دارم
- حبوبات و سویا دشمن فشار خون بالا
- عکس ها و اسامی / جوانی و پیری همه همسران شاه پهلوی / فرح دیبا بد چهره ترین ملکه ایران !
- فال و طالع بینی امروز 7 خرداد 1405
- تفسیر فال حافظ امروز 7 خرداد 1405
- فال ابجد امروز 7 خرداد 1405
- فیلم / رونمایی از رضا گلزار از همسرش آیسان خانم : من الان تو خونه خانمم میگه دقیق بگو چند روزه که ازدواج کردیم / چه قدر دل آقای سوپراستار پره
- عکس های همسر شهیدِ آیت الله مجتبی خامنه ای و 2 نوه کوچولوی شهید رهبری انقلاب / زهرای 14 ماهه و مصباح الهدی 7 ساله و زهرا حداد عادل عروس رهبر شهید
- عکس/ تغییر چهره بازیگران سریال کهنه سوار بعد 24 سال! / از آناهیتا همتی تا مریلا زارعی و شیوا ابراهیمی
- لوازم آرایش ضد آب ممنوع!
- دانلود آهنگ محسن چاوشی به نام نخل های بی سر
- قیف فروش چیست؟ + فیلم